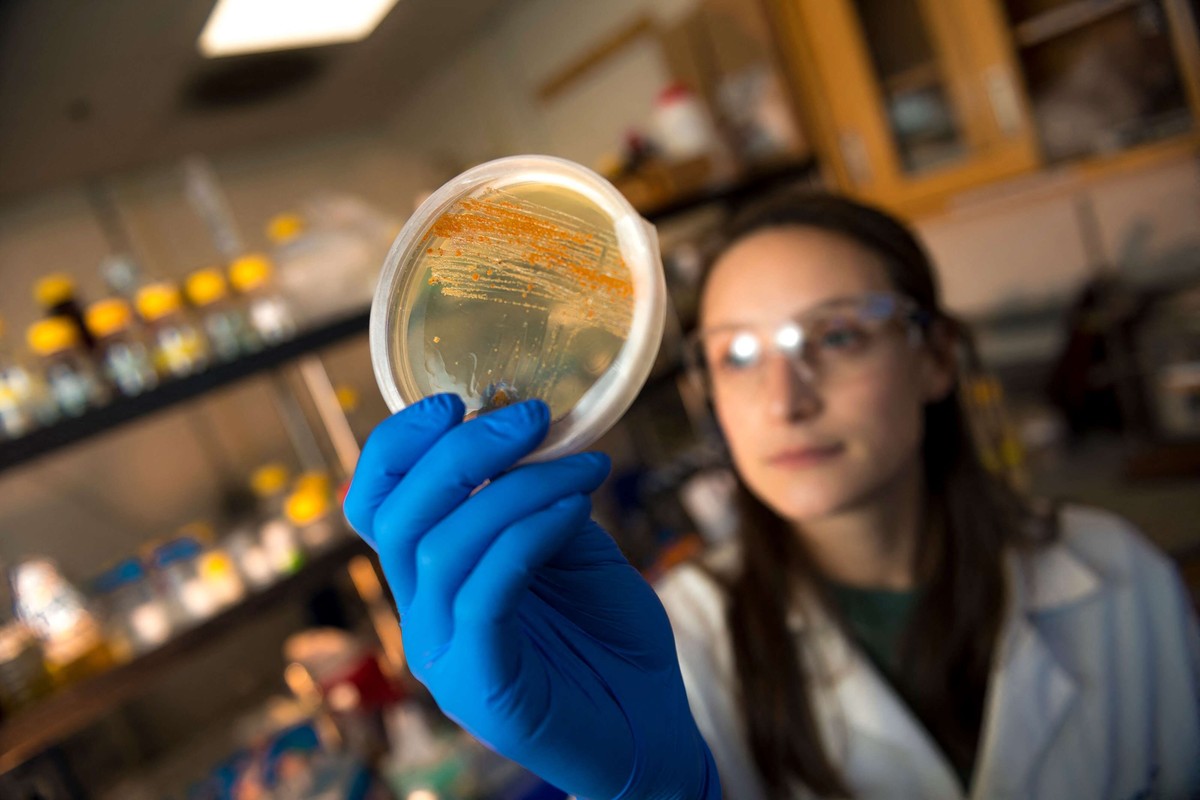
بكتيريا

داوني بالتي كانت هي الداء، الفيروسات لعلاج المكورات العنقودية!
أتلانتا - تشير نتائج تجربة سريرية في منتصف مراحلها إلى أن فيروسات دقيقة لا تصيب سوى البكتيريا وتقتلها يمكن أن تساعد في علاج العدوى المميتة في مجرى الدم الناتجة عن المكورات العنقودية الذهبية.
واختبر الباحثون هذا النهج العلاجي على 42 مريضا مصابا ببكتيريا المكورات العنقودية الذهبية المقاومة للمضادات الحيوية، والتي انتشرت من الدم إلى الأنسجة، ووصفوا تلك العدوى بأنها "واحدة من أخطر أنواع العدوى البكتيرية وأكثرها صعوبة في العلاج".
وتلقى ثلثا المرضى علاجا عبر الوريد يتضمن مزيجا من الفيروسات المعروفة باسم ملتهمات البكتيريا، والذي تطوره شركة أرماتا للأدوية، بينما تلقى الثلث الآخر علاجا وهميا.
وحصل جميع المرضى المشاركين في التجربة أيضا على أفضل العلاجات المتاحة من المضادات الحيوية.
واحدة من أخطر أنواع العدوى البكتيرية
وحقق المرضى الذين تلقوا مزيج الفيروسات المعروفة باسم ملتهمات البكتيريا إلى جانب المضادات الحيوية نجاحا سريريا أعلى مقارنة بمن تلقوا المضادات الحيوية فقط وذلك في عدة مراحل خلال فترة العلاج.
فعلى سبيل المثال، بلغت نسبة الاستجابة في اليوم الثاني عشر 88 بالمئة لدى المجموعة التي تلقت العلاج الفيروسي مقابل 58 بالمئة في مجموعة العلاج الوهمي.
وقال الباحثون في اجتماع لأطباء الأمراض المعدية في مدينة أتلانتا الأميركية إن المرضى الذين تلقوا علاجا بملتهمات البكتيريا سجلوا نتائج أفضل تمثلت في تراجع معدلات الانتكاس وسرعة تسجيل نتائج سلبية في فحوصات زراعة الدم وتحسن أسرع في الأعراض إلى جانب تقليص مدة البقاء في وحدات العناية المركزة والمستشفيات.
وقال الدكتور لورين ميلر رئيس الدراسة من مركز هاربور-يو.سي.إل.إيه الطبي في بيان "تقدم هذه النتائج مبررا قويا للانتقال إلى المرحلة الثالثة من الدراسة، وتشير إلى احتمال حدوث تحول جذري في طريقة علاج العدوى المقاومة للمضادات الحيوية".
وأضاف "يمكن أن تصبح العلاجات عالية النقاء المعتمدة على ملتهمات البكتيريا معيارا جديدا للاعتناء بالمرضى الذين يواجهون هذه الحالة المهددة للحياة".